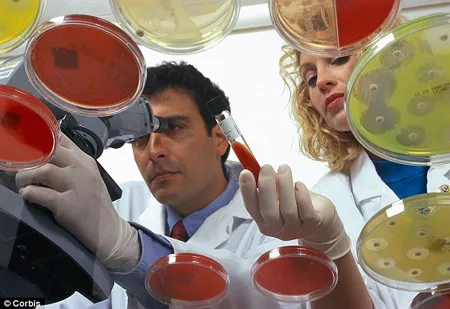
Phát hiện vi khuẩn 34.000 năm tuổi còn sống

Nhà nghiên cứu Brian Schubert, thuộc Đại học Hawaii (Mỹ) đã phát hiện ra loại vi khuẩn có từ 34.000 năm trước. Loại vi khuẩn này được nhà nghiên cứu tìm thấy dưới lớp cát tại thung lũng Death phía đông bang California.
Các nhà khoa học đã phát hiện loại vi khuẩn 34.000 năm tuổi.
Vi khuẩn cổ đại mới phát hiện bị “giam” trong khối tinh thể muối vẫn đang sống nhưng kích thước đã teo nhỏ lại và đang trong trạng thái ngủ đông. Sở dĩ nó tồn tại được trong…34.000 năm qua nhờ ăn một loại tảo có trong khối chất lỏng.
Đây được xem như loại vi khuẩn lâu đời nhất trái đất mới được tìm thấy.
Đăng Hưng

























